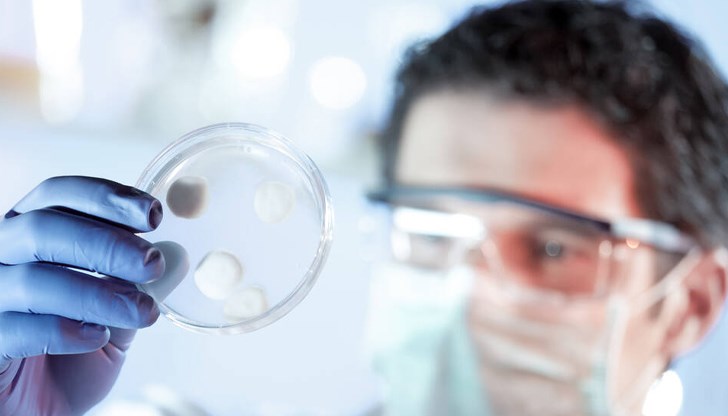
Смята се, че захарта е причинила развитието на бактерии, които причиняват заболяването по зъбите Смята се, че захарта е причинила развитието на бактерии, които причиняват заболяването по зъбите

Откога съществува зъбният кариес при човека?
- Редактор: Мирослава Бонева
- Коментари: 0
Смята се, че захарта е причинила развитието на бактерии, които причиняват заболяването по зъбите
Учени откриха доказателства за наличието на бактерии, които причиняват кариес и заболявания на венците, в човешки кътници на 4000 години, предаде ДПА и NOVA.
В останките от зъби, открити във варовикова пещера в графство Лимерик, Ирландия, изследователите установяват "безпрецедентно количество" ДНК на Streptococcus mutans - вид бактерия в човешката уста, която причинява кариеси. Смята се, че моларите са принадлежали на човек от бронзовата епоха.
Екипът открива и други видове микроби, свързани със заболявания на венците, включително Tannerella forsythia. На базата на анализи учените успяват да реконструират геномите - пълен набор от генетичен материал на древните бактерии.
Изследователите са на мнение, че проучването им ще помогне да се разбере как се е развивала хранителния режим на хората през вековете, особено във връзка с консумацията на захар.
Според тях е "изключително рядко" да се открие Streptococcus mutans в проби от древни зъби, тъй като тази бактерия произвежда киселини, които причиняват кариес, но също така и разгражда ДНК.
Изследователите твърдят, че условията в пещерата, която е хладна, суха и алкална, може да са спомогнали за "изключителното запазване" на ДНК на бактериите.
"Бяхме много изненадани да видим такова голямо количество мутации в този зъб на 4000 години. Това е изключително рядко срещано откритие и предполага, че този човек е бил изложен на висок риск от развитие на кариес непосредствено преди смъртта си", казва Лара Касиди от дъблинския "Тринити колидж".
Изследователите смятат, че "голямото изобилие" на ДНК на бактерията в корена на един зъб може потенциално да показва също дисбаланс или нарушение в микробната общност в устата.
Те казват, на базата на ДНК анализ, че двете бактерии са се променили драстично от бронзовата епоха до днес. Според тях любовта на човечеството към захарта през последните години може да е оказала "прекомерно голямо влияние" върху тяхната еволюция.
Streptococcus mutans е в състояние да влияе върху захарите от храните, попаднали в зъбите, за да произвежда киселини. Това позволява на тази бактерия да "се развива", като ѝ предимство пред други подобни видове бактерии, допълват изследователите.
Данните от изследването са публикувани в изданието Molecular Biology and Evolution.
Археолозите наблюдават увеличение на зъбните кариеси в скелетни останки, когато хората са започнали да се занимават със зърнопроизводство, но зъбният кариес е станал много по-разпространен през ранния съвременния период, започнал около 1500 г.






















